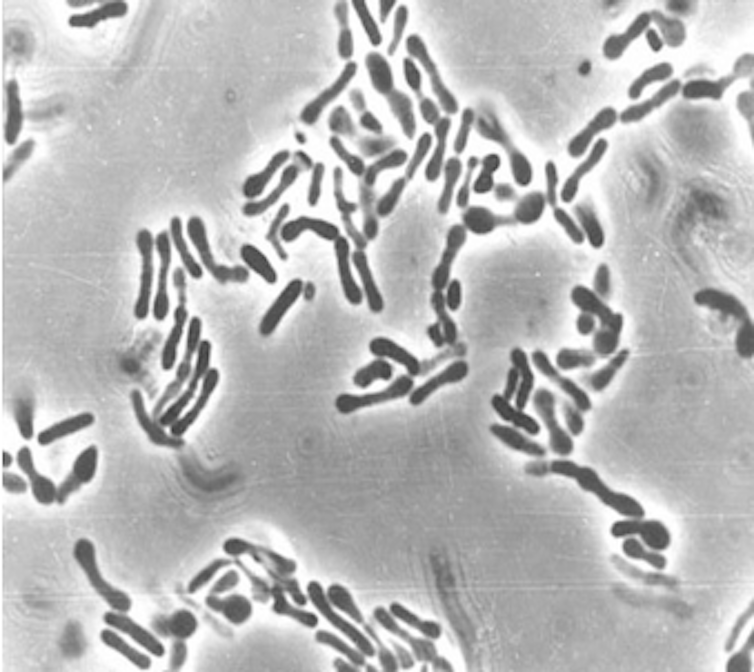

Multiple sclerosis is a disease that results when the immune system mistakenly attacks the brain and spinal cord. It affects nearly one million people in the U.S. and over 2.8 million worldwide. While genetics play a role in the risk of developing multiple sclerosis, environmental factors such as diet, infectious disease and gut health are major contributors.
The environment plays a key role in determining who develops multiple sclerosis, and this is evident from twin studies. Among identical twins who share 100% of their genes, one twin has a roughly 25% chance of developing MS if the other twin has the disease. For fraternal twins who share 50% of their genes, this rate drops to around 2%.
Scientists have long suspected that gut bacteria may influence a person’s risk of developing multiple sclerosis. But studies so far have had inconsistent findings.
To address these inconsistencies, my colleagues and I used what researchers call a bedside-to-bench-to-bedside approach: starting with samples from patients with multiple sclerosis, conducting lab experiments on these samples, then confirming our findings in patients.
In our newly published research, we found that the ratio of two bacteria in the gut can predict multiple sclerosis severity in patients, highlighting the importance of the microbiome and gut health in this disease.

Zhang et al/Microbial Biotechnology, CC BY-SA
Bedside to bench
First, we analyzed the chemical and bacterial gut composition of patients with multiple sclerosis, confirming that they had gut inflammation and different types of gut bacteria compared with people without multiple sclerosis.
Specifically, we showed that a group of bacteria called Blautia was more common in multiple sclerosis patients, while Prevotella, a bacterial species consistently linked to a healthy gut, was found in lower amounts.
In a separate experiment in mice, we observed that the balance between two gut bacteria, Bifidobacterium and Akkermansia, was critical in distinguishing mice with or without multiple sclerosis-like disease. Mice with multiple sclerosis-like symptoms had increased levels of Akkermansia and decreased levels of Bifidobacterium in their stool or gut lining.
Bench to bedside
To explore this further, we treated mice with antibiotics to remove all their gut bacteria. Then, we gave either Blautia, which was higher in multiple sclerosis patients; Prevotella, which was more common in healthy patients; or a control bacteria, Phocaeicola, which is found in patients with and without multiple sclerosis. We found that mice with Blautia developed more gut inflammation and worse multiple sclerosis-like symptoms.
Even before symptoms appeared, these mice had low levels of Bifidobacterium and high levels of Akkermansia. This suggested that an imbalance between these two bacteria might not just be a sign of disease, but could actually predict how severe it will be.
We then examined whether this same imbalance appeared in people. We measured the ratio of Bifidobacterium adolescentis and Akkermansia muciniphila in samples from multiple sclerosis patients in Iowa and participants in a study spanning the U.S., Latin America and Europe.
Our findings were consistent: Patients with multiple sclerosis had a lower ratio of Bifidobacterium to Akkermansia. This imbalance was not only linked to having multiple sclerosis but also with worse disability, making it a stronger predictor of disease severity than any single type of bacteria alone.
Paola Mattarelli and Monica Modesto/Katz Lab via Flickr, CC BY-NC
How ‘good’ bacteria can become harmful
One of the most interesting findings from our study was that normally beneficial bacteria can turn harmful in multiple sclerosis. Akkermansia is usually considered a helpful bacterium, but it became problematic in patients with multiple sclerosis.
A previous study in mice showed a similar pattern: Mice with severe disease had a lower Bifidobacterium-to-Akkermansia ratio. In that study, mice fed a diet rich in phytoestrogens – chemicals structurally similar to human estrogen that need to be broken down by bacteria for beneficial health effects – developed milder disease than those on a diet without phytoestrogens. Previously we have shown that people with multiple sclerosis lack gut bacteria that can metabolize phytoestrogen.
Although the precise mechanisms behind the link between the Bifidobacterium-to- Akkermansia ratio and multiple sclerosis is unknown, researchers have a theory. Both types of bacteria consume mucin, a substance that protects the gut lining. However, Bifidobacterium both eats and produces mucin, while Akkermansia only consumes it. When Bifidobacterium levels drop, such as during inflammation, Akkermansia overconsumes mucin and weakens the gut lining. This process can trigger more inflammation and potentially contribute to the progression of multiple sclerosis.
Our finding that the Bifidobacterium-to-Akkermansia ratio may be a key marker for multiple sclerosis severity could help improve diagnosis and treatment. It also highlights how losing beneficial gut bacteria can allow other gut bacteria to become harmful, though it is unclear whether changing levels of certain microbes can affect multiple sclerosis.
While more research can help clarify the link between the gut microbiome and multiple sclerosis, these findings offer a promising new direction for understanding and treating this disease.![]()
Ashutosh Mangalam, Associate Professor of Pathology, University of Iowa
This article is republished from The Conversation under a Creative Commons license. Read the original article.